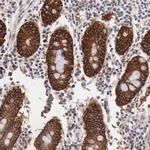
XPNPEP3 Antibody in Immunohistochemistry (IHC)

Search
Invitrogen
XPNPEP3 Polyclonal Antibody
{{$productOrderCtrl.translations['antibody.pdp.commerceCard.promotion.promotions']}}
{{$productOrderCtrl.translations['antibody.pdp.commerceCard.promotion.viewpromo']}}
{{$productOrderCtrl.translations['antibody.pdp.commerceCard.promotion.promocode']}}: {{promo.promoCode}} {{promo.promoTitle}} {{promo.promoDescription}}. {{$productOrderCtrl.translations['antibody.pdp.commerceCard.promotion.learnmore']}}
产品信息
PA5-51402
种属反应
宿主/亚型
分类
类型
抗原
偶联物
形式
浓度
规格
纯化类型
保存液
内含物
保存条件
运输条件
RRID
产品详细信息
Immunogen sequence: THPHLLRPGE VTPGLSQVEY ALRRHKLMSL IQKEAQGQSG TDQTVVVLSN PTYYMSNDIP YTFHQDNNFL YLCGFQEPDS ILVLQSLPGK QLPSHKAILF VPRRDPSREL WDGPRSGTDG AIALTGVDEA YTLEEFQHLL PKMKAETNMV WYDWMRPSHA QLHSDYMQ
Highest antigen sequence identity to the following orthologs: Mouse - 92%, Rat - 90%.
靶标信息
XPNPEP3, also known as X-Prolyl Aminopeptidase 3, is a gene located on chromosome 22q that encodes an enzyme involved in the processing of mitochondrial matrix proteins. The enzyme is classified under the M24B subfamily of metallopeptidases, which specifically remove the N-terminal amino acid from oligopeptides where the penultimate residue is proline. XPNPEP3 is implicated in conditions such as cystic kidney disease and participates in TNF-TNFR2 cellular signaling pathways. Its yeast and plant homologs, like Icp55, perform similar functions by stabilizing proteins after import into the mitochondrial matrix. Mutations in XPNPEP3 are associated with defects in ciliary structure and function, contributing to the phenotypic spectrum seen in nephronophthisis-related ciliopathies (NPHP-RCs). The crystal structure of XPNPEP3 has been resolved at 1.65 A resolution, revealing its interaction with inhibitors such as apstatin. Furthermore, XPNPEP3 is identified as a transcriptional target of the canonical Wnt/beta-catenin signaling pathway, with elevated transcript levels observed in tumors exhibiting activated Wnt signaling.
仅用于科研。不用于诊断过程。未经明确授权不得转售。
篇参考文献 (0)
生物信息学
蛋白别名: Aminopeptidase P3; APP3; dJ1057D18.1; Intermediate Cleaving Peptidase 55; LOC63929; probable Xaa-Pro aminopeptidase 3; unnamed protein product; X-Pro aminopeptidase 3; X-prolyl aminopeptidase (aminopeptidase P) 3, putative; X-prolyl aminopeptidase 3, mitochondrial; Xaa-Pro aminopeptidase 3
基因别名: APP3; ICP55; NPHPL1; XPNPEP3
UniProt ID: (Human) Q9NQH7, (Rat) B5DEQ3
Entrez Gene ID: (Human) 63929, (Rat) 685823